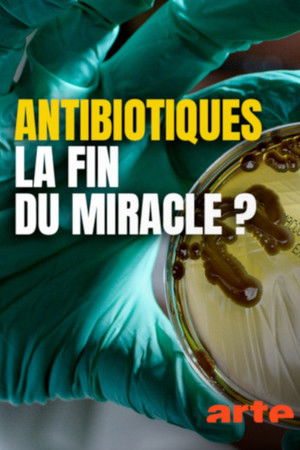

Movie Description
Resistance Fighters – Die globale Antibiotika-Krise
(2019)Overview
The UN General Assembly regards antibiotic-resistance as a "global and most urgent threat". The WHO alarms that we could fall back into a "post-antibiotic age". The film tells us how we got there: It is a story about how negligence, greed, and short-sightedness have rendered the lifesaving effects of antibiotics powerless. It is a science-thriller about disillusioned, fighting doctors, rebellious scientists, patients wrestling with life-threatening diseases and diplomats searching for a global solution. They all are Resistance Fighters.
Featured Crew
- Director : Michael Wech
- Producer : Leopold Hoesch
- Writer : Michael Wech
- Editor : Michael Scheffold
- Cast : Patrick Winczewski,Tanveer Ahmed,Edward Allera,Uwe Behrens,Juan José Gómez Camacho,Slava Epstein,Peter Greenhouse,Tom Grumbly,Alexander Kallen,Maryn McKenna,Paul Menzies,Gerd-Ludwig Meyer,Richard Novick,Nolan Stone,Randall Todd,Kevin Brown,Lei Chen,David Cromwell,Sally Davies,Steven Finch,John Lynch,Jim O'Neill,David Ricci,Ann Tucker,Timothy Walsh
Cast
Narrator (voice)
Self - Ass. Professor Plast. Surgery
Self - Pharmacist / Former Attorney
Self - MUT Alliance
Self - UN Ambassador
Self - Professor at Northeastern University
Self - Sexual Health expert
Self - Chairman SoAR Foundation (USA)
Self - Centres of Diseas Control and Preventiond
Self - Science journalist
Self - Local Historian Middlesbrough (GB)
Self - Dialysist practitioner
Self - Microbioligist
Self - Cattle Breeder
Self - Chief Officer CDC Reno
Self - Medical Historian
Self - CDC Specialist Reno
Self - Former Doctor US Forces
Chief Medical Officer (GB)
Self - Relative of a victim
Self - Doctor
Self - Economist
Self - Victim
Self - Former Nurse Middlesbrough (GB)
Self - Professor of Medical Microbiology
Recommendations
The Class of ‘92
7.1
The War Room
6.8
Heart of a Dog
6.5
End Game
7.1
Forks Over Knives
7.14
John Candy: I Like Me
7.881
I Am: Celine Dion
7.667
Thriller 40
8.642
Fed Up
7.311
Sidney
7
Facts
Original TitleResistance Fighters – Die globale Antibiotika-Krise
Status Released
Release Information
-
2019-03-24
Original LanguageEnglish
Runtime 01h 35m
Homepagehttps://www.amr-film.com/
Production CompaniesARTE,ZDF,Broadview Pictures
Genres
- Documentary